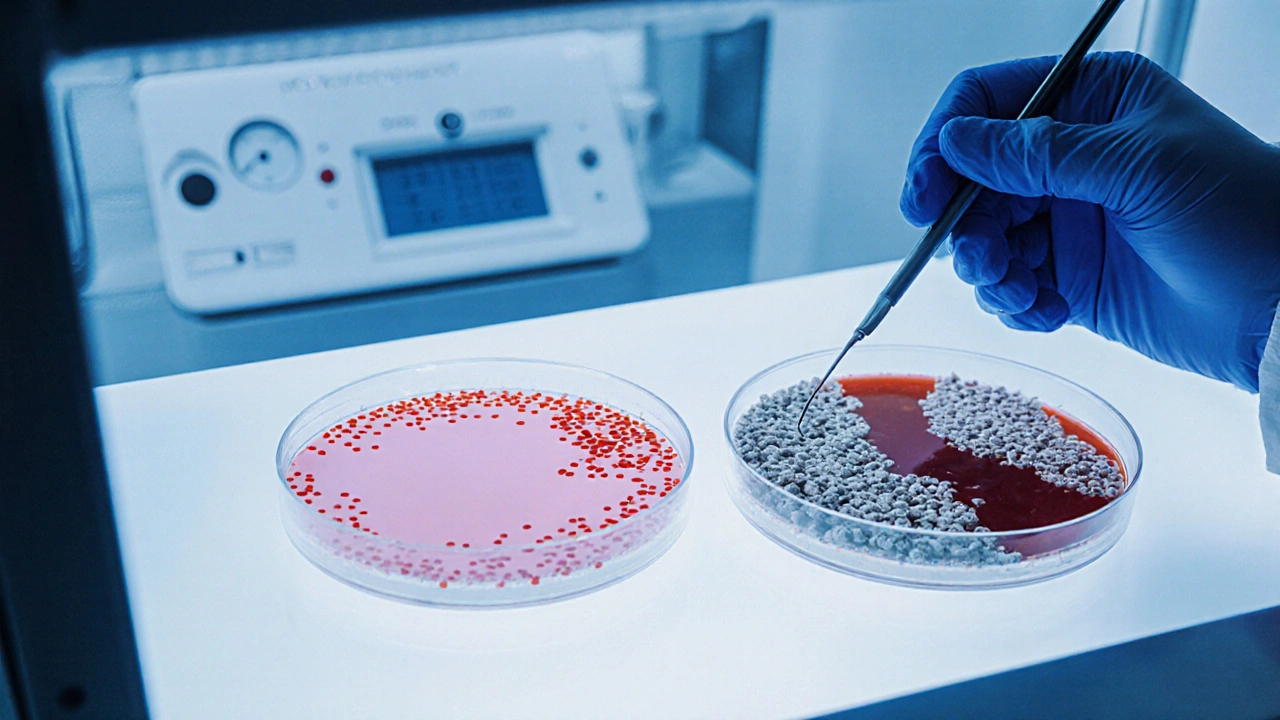

Kalkulátor doby výsledků bakteriologického vyšetření moči
Výpočet doby výsledku bakteriologického vyšetření moči
Chcete vědět, jak rychle získat výsledek bakteriologického vyšetření moči a co všechno se během testu děje? V tomto článku si projdeme celý proces od odběru až po finální zprávu, vysvětlíme, proč se dobu může lišit, a poradíme, co dělat, když čekáte na výsledek.
Bakteriologické vyšetření moči je laboratorní test, který identifikuje a kvantifikuje bakterie v moči, což pomáhá diagnostikovat infekce močových cest (IČK) a další onemocnění.
Co zahrnuje bakteriologické vyšetření moči?
Test se skládá z několika kroků, které provádí Mikrobiologická laboratoř specializované zařízení vybavené kultivačními médii a moderní diagnostickou technikou. Základní částí je kultivace - moč se rozlije na agarová plotna, která podporuje růst různých bakterií. Po inkubaci se pozoruje, zda se vyvinou kolonie a jaké jsou jejich charakteristiky.
Kroky v laboratoři od odběru po výsledek
- Odběr vzorku - ideální je čistý střední proud moči, odebraný v čisté nádobě, nejlépe během první hodiny po probuzení.
- Transport do laboratoře - vzorek by měl být doručen během 2 hodin, pokud je uchováván v chladničce, může vydržet až 4 hodiny.
- Příprava kultivačních médií - nejčastěji se používá MacConkeyův agar pro gramnegativní bakterie a krevní agar pro grampozitivní.
- Inkubace - při 35‑37 °C po dobu 24-48 hodin. Některé pomalejší bakterie vyžadují až 72 hodin.
- Identifikace - vizuální posouzení kolonií, biochemické testy (API, VITEK) nebo molekulární metody (PCR).
- Antibiogram - pokud jsou bakterie identifikovány, provádí se test citlivosti na antibiotika, aby lékař mohl předepsat správnou terapii.
- Vyhotovení zprávy - laboratorní technik zapíše typ bakterie, počet CFU/ml (kolonie tvořící jednotky) a výsledky antibiotogramu.
Jak dlouho obvykle čekat na výsledek?
Standardní kultura trvá 24-48 hodin. V praxi se často uvádí:
- 24 hodin - pokud je výsledek negativní (žádný růst) a laboratorní kapacity jsou vysoké.
- 48 hodin - pokud se objeví růst a je potřeba provést identifikaci a antibiotogram.
- 72 hodin - v případě pomalejších bakterií (např. Enterococcus, některé anaerobní druhy).
V některých moderních laboratořích je k dispozici rychlý PCR test, který dokáže detekovat přítomnost nejčastějších patogenů během 3-6 hodin, avšak tato metoda nezahrnuje antibiotogram.
Faktory, které mohou prodloužit dobu vyšetření
- Vzdálenost a doba přepravy - pokud vzorek cestuje z jiného města, může se prodloužit čas doručení.
- Počet vzorků v laboratoři - v období vysoké poptávky (např. podzimní infekce) může být kapacita omezena.
- Neobvyklé bakterie - pomalejší růst vyžaduje delší inkubační dobu.
- Kontaminace - pokud je vzorek kontaminován, může být nutné odebrat nový a proces se restartuje.
Různé metodiky a jejich rychlost
| Metoda | Čas potřebný | Citlivost | Náklady |
|---|---|---|---|
| Klasická kultivace | 24‑48 h | Vysoká (≥10^3 CFU/ml) | Střední |
| Rozšířená kultivace (72 h) | 72 h | Vysoká i pro pomalejší bakterie | Střední |
| PCR multiplex | 3‑6 h | Velmi vysoká (detekce DNA) | Vysoké |
| Urinní test s automatickým čtečkem | 30‑60 min | Střední (přítomnost leukocytů, nitritů) | Nízké |
Volba metody závisí na klinickém kontextu: pokud je potřeba rychlá orientace, často se použije rychlý test nitritů a leukocytů, ale pro správnou antibiotickou terapii je nezbytná kultura a antibiotogram.

Co dělat během čekání na výsledek?
- Dodržujte předepsanou léčbu - i pokud výsledek ještě není k dispozici, pokud lékař předepsal empirické antibiotikum, pokračujte v léčbě.
- Pijte dostatek tekutin - pomáhá vyplavit bakterie z močových cest.
- Sledujte příznaky - pokud dojde ke zhoršení (bolest, horečka, krvavá moč), kontaktujte okamžitě svého lékaře.
- Ukládejte vzorek správně - pokud bylo nutné vzorek opakovat, použijte čistou nádobu a odeberte střední proud.
Kdy je nutné kontaktovat lékaře po odeslání vzorku?
Pokud po 48 hodinách nedostanete žádnou informaci a vaše příznaky přetrvávají, nebo se objeví nové symptomy (např. vysoká horečka, bolest zad), je vhodné volat. Rovněž pokud jste během čekání dostali jiný výsledek (např. pozitivní dipstick test) a nejste si jisti, zda je současná léčba adekvátní.
Často kladené otázky
Jak dlouho mohu uchovávat moči před odesláním do laboratoře?
Ideální je dodat vzorek během 2 hodin. Pokud není možné, uložit vzorek v chladničce (2‑8 °C) a doručit do 4 hodin je bezpečné.
Co znamená výsledek ‘>10^5 CFU/ml’?
Hodnota vyšší než 100 000 kolonií tvořících jednotek na mililitr naznačuje významnou bakteriální infekci, obvykle vyžadující antibiotickou léčbu.
Mohu si výsledek zjistit online?
Mnoho českých laboratoří nabízí elektronické portály, kde po zadání identifikačního čísla můžete stáhnout PDF zprávy během 24 hodin od ukončení analýzy.
Proč se měří i kyselina močová při bakteriologickém testu?
Kyselina močová není součástí bakteriologického vyšetření, ale často se měří současně v biochemickém panelu, aby se vyloučily jiné metabolické poruchy.
Jaký je rozdíl mezi dipstick testem a bakteriologickou kulturou?
Dipstick test poskytuje rychlou indikaci přítomnosti leukocytů nebo nitritů (do 30 min), ale nedává informaci o druhu bakterie ani o citlivosti na antibiotika, což nabízí jen kultura.
Na závěr je dobré vědět, že standardní bakteriologické vyšetření moči poskytuje spolehlivé informace během 1‑2 dnů, ale rychlé testy a moderní metody dokážou výsledek urychlit na několik hodin. Vše záleží na konkrétních okolnostech a potřebě detailní identifikace.
